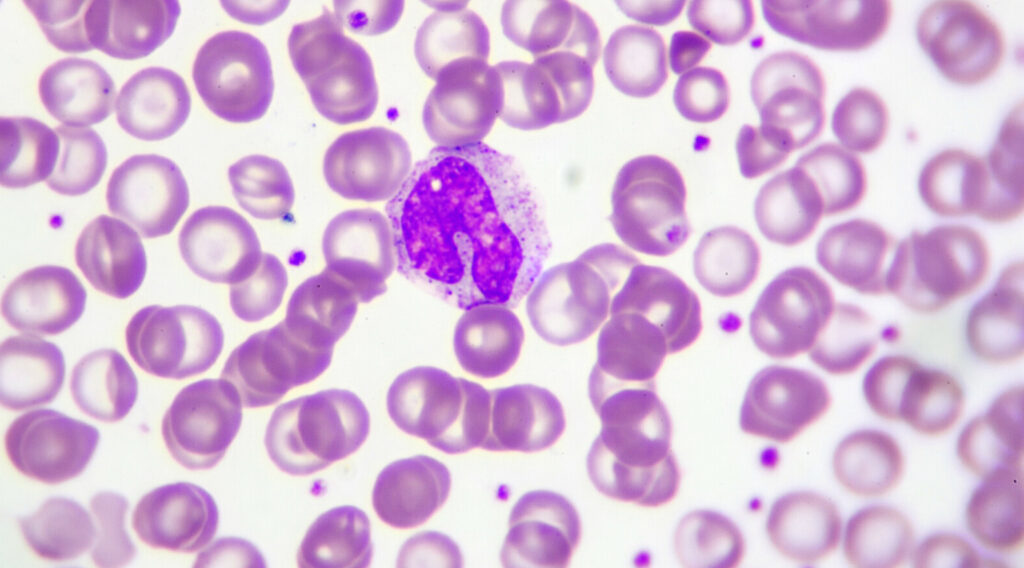
Toutes les monocytoses ne se ressemblent pas…

Diagnostic des infections respiratoires
Dans le panel bactérien, on retrouve le covid-19, les grippes A et B et le VRS.
Lire la suite
Accueil / Articles pro

Recherche en cours...